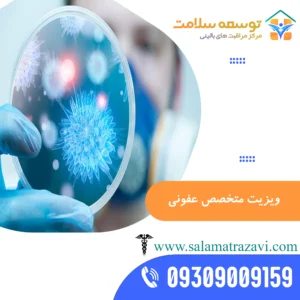
ویزیت متخصص عفونی در منزل مشهد

پزشک متخصص در منزل مشهد
نمایش 1–9 از 13 نتیجه
- پزشک متخصص در منزل مشهدخدمات پزشکی در منزل مشهدویزیت فوق تخصص

IVF(آی وی اف) در مشهد
رایگان - پزشک متخصص در منزل مشهدخدمات پزشکی در منزل مشهد

متخصص اطفال در منزل مشهد
رایگان - پزشک متخصص در منزل مشهدخدمات پزشکی در منزل مشهد

متخصص اورولوژی در منزل مشهد
رایگان - پزشک متخصص در منزل مشهدخدمات پزشکی در منزل مشهد

متخصص داخلی در منزل مشهد
رایگان - پزشک متخصص در منزل مشهدخدمات پاراکلینیکی در مشهدخدمات پزشکی در منزل مشهد

متخصص رژیم درمانی در منزل مشهد
رایگان - پزشک متخصص در منزل مشهدخدمات پزشکی در منزل مشهد

متخصص روانپزشک در منزل مشهد
رایگان - پزشک متخصص در منزل مشهدخدمات پزشکی در منزل مشهد

متخصص زنان در منزل مشهد
نمره 5.00 از 5رایگان - پزشک متخصص در منزل مشهدخدمات پزشکی در منزل مشهد

متخصص عفونی در منزل مشهد
رایگان - پزشک متخصص در منزل مشهدخدمات پزشکی در منزل مشهد

متخصص کلیه و مجاری ادراری در منزل مشهد
رایگان